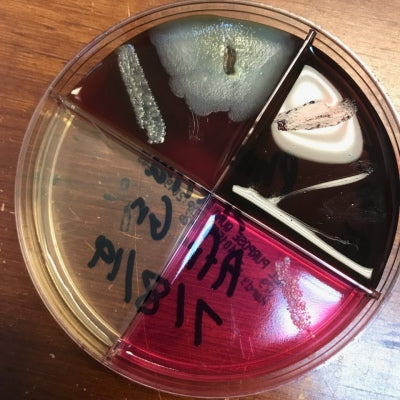
Donate $100 for bacterial cultures and other tests

1
/
of
1
Donate $100 for bacterial cultures and other tests
Donate $100 for bacterial cultures and other tests
Regular price
$ 100.00
Regular price
Sale price
$ 100.00
Unit price
/
per
Couldn't load pickup availability
A donation of $100 will cover bacterial cultures or other diagnostic tests needed for a parrot in Phoenix Landing Foundation's adoption program.
Share